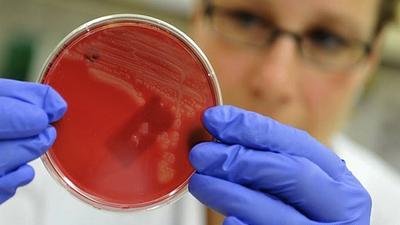
saude-2.jpg

Mourinho reage a críticos após derrotas do Manchester United
22/09/2016, 12:12
O técnico do Manchester United, José Mourinho, confrontou os "Einsteins" do futebol por criticá-lo após uma sequência de três derrotas consecutivas de seu time na Liga Inglesa